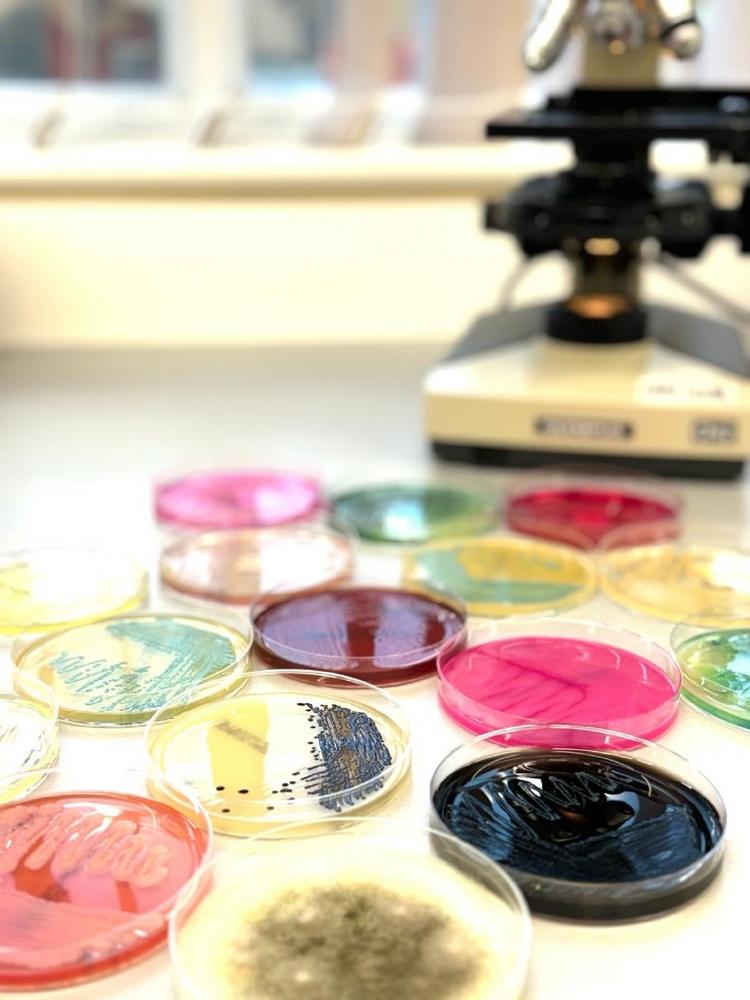

Sally Bellekom, Director of SMS Ltd commented “We are already receiving enquiries for the above testing as a result of the amendment to the EU Commission Regulation (EC) No 2073/2005 on microbiological criteria for foodstuffs, which will require Listeria monocytogenes to be not detected in 25 grams of ready-to-eat (RTE) foods throughout their shelf-life. This stricter rule will apply, unless a food business operator can demonstrate that the level of Listeria monocytogenes will not exceed 100 cfu/g, during the entire shelf life of the product. This will be effective from 1st July 2026’’.
If you would like further details and more information on how we can perform Listeria monocytogenes challenge testing on your products, in preparation for the above legislative changes, please contact the SMS Technical Team.
To download our latest UKAS Schedule of Accreditation please follow the link below;
https://www.ukas.com/wp-content/uploads/schedule_uploads/00002/1922Testing-Single.pdf
Tentamus Group GmbH
An der Industriebahn 26
13088 Berlin
Telefon: +49 (30) 206038-230
Telefax: +49 (30) 206038-190
http://www.tentamus.com
Director Southern Microbiological Services
Telefon: +44 (1823) 662062
E-Mail: sally.bellekom@tentamus.com
![]()